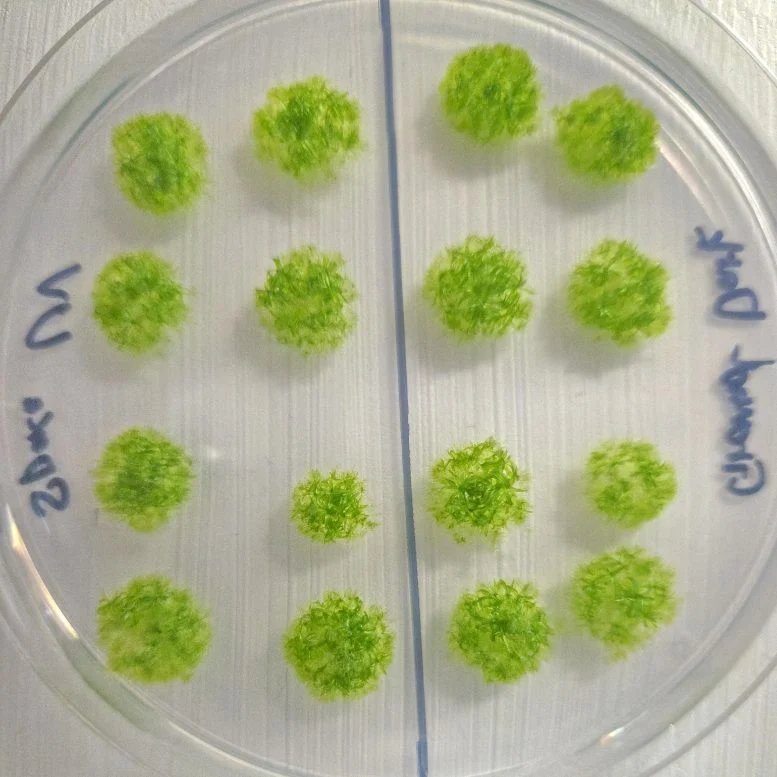
أذهل العلماء عندما بقي موس على قيد الحياة لمدة 9 أشهر في الفضاء المفتوح 2 Germinated Moss Spores

أذهل العلماء عندما بقي موس على قيد الحياة لمدة 9 أشهر في الفضاء المفتوح
اكتشف الباحثون أن أبواغ الطحالب يمكنها البقاء على قيد الحياة لمدة عام تقريبًا عند تعرضها للفضاء مباشرةً.
وعلى الرغم من الأشعة فوق البنفسجية الشديدة وتقلبات درجات الحرارة، ظلت معظم الجراثيم قابلة للحياة عند عودتها إلى الأرض. ويعمل غلافها الواقي كدرع طبيعي، مما يتيح لها المرونة التي لم يتوقعها العلماء. تفتح النتائج الأبواب أمام استخدام النباتات شديدة التحمل للزراعة المستقبلية خارج العالم.
مرونة الطحلب من الأرض إلى الفضاء
تُعرف الطحالب بقدرتها على الازدهار في بعض أقسى المواقع على هذا الكوكب، بدءًا من سلاسل الجبال العالية مثل جبال الهيمالايا وحتى التضاريس الحارقة في وادي الموت، بالإضافة إلى سهول التندرا المتجمدة في القطب الجنوبي وحتى الأسطح الباردة للبراكين النشطة. لقد ألهمت صلابتها الرائعة الباحثين بإرسال النباتات البوغية الطحلبية، وهي هياكل تكاثرية تحتوي على الأبواغ، إلى ما قد يكون البيئة الأكثر قسوة على الإطلاق: الفضاء الخارجي. الدراسة التي نشرت في iScience اليوم (20 نوفمبر)، ذكرت أن أكثر من 80٪ من الجراثيم بقيت لمدة 9 أشهر خارج الأرض محطة الفضاء الدولية (محطة الفضاء الدولية) وعادت إلى الأرض وهي لا تزال قادرة على التكاثر. يمثل هذا أول مثال موثق لنبات بري مبكر ينجو من التعرض المباشر طويل الأمد للفضاء.
يقول توموميتشي فوجيتا، المؤلف الرئيسي للدراسة: “معظم الكائنات الحية، بما في ذلك البشر، لا يمكنها البقاء على قيد الحياة ولو لفترة وجيزة في فراغ الفضاء”. جامعة هوكايدو. “ومع ذلك، احتفظت جراثيم الطحالب بحيويتها بعد تسعة أشهر من التعرض المباشر. وهذا يقدم دليلا صارخا على أن الحياة التي تطورت على الأرض تمتلك، على المستوى الخلوي، آليات جوهرية لتحمل ظروف الفضاء.”
بدأ فوجيتا لأول مرة في التفكير في فكرة اختبار الطحالب في الفضاء أثناء فحص تطور النبات وتطوره. بدا أن الطحالب قادرة بشكل استثنائي على الاستقرار في الأماكن التي تتحدى معظم أشكال الحياة. “بدأت أتساءل: هل يمكن لهذه المحطة الصغيرة ولكنها قوية بشكل ملحوظ أن تبقى على قيد الحياة في الفضاء؟”
سؤال جذري: هل يستطيع الطحلب البقاء على قيد الحياة في الفضاء؟
لاستكشاف هذا السؤال، كشف فوجيتا وزملاؤه فتح فيسكوميتريوم، وتسمى أيضًا طحالب الأرض المنتشرة، إلى بيئة فضائية محاكاة تتضمن الأشعة فوق البنفسجية المكثفة، والتغيرات الشديدة في درجات الحرارة، وضغط مستوى الفراغ.
قارن الفريق بقاء ثلاثة هياكل طحالب: البروتينات (الطحالب اليافعة)، والخلايا الحاضنة (الخلايا الجذعية المتخصصة التي تتشكل أثناء الإجهاد)، والنباتات البوغية (الأبواغ المغلفة). كان هدفهم هو تحديد الشكل الذي يتمتع بأعلى مرونة في ظل ظروف شبيهة بالفضاء.
اختبار الهياكل الطحلبية ضد الظروف القاسية
يقول فوجيتا: “لقد توقعنا أن تتسبب ضغوط الفضاء مجتمعة، بما في ذلك الفراغ، والإشعاع الكوني، والتقلبات الشديدة في درجات الحرارة، والجاذبية الصغرى، في أضرار أكبر بكثير من أي ضغوط منفردة”.
وأظهرت نتائجهم أن الأشعة فوق البنفسجية كانت العامل الأكثر ضررا. كانت الفطريات البوغية أكثر مقاومة بشكل كبير من الأشكال الأخرى. ماتت الطحالب الصغيرة تحت التعرض الشديد للأشعة فوق البنفسجية ودرجات الحرارة القصوى، في حين كان أداء الخلايا الحاضنة أفضل إلى حد ما. ومع ذلك، أظهرت الجراثيم الموجودة داخل الفطريات البوغية قدرة تحمل أكبر للأشعة فوق البنفسجية بمقدار 1000 مرة تقريبًا. كما أنها ظلت قابلة للحياة بعد تحمل درجة حرارة -196 درجة مئوية لأكثر من أسبوع وبعد قضاء شهر عند درجة حرارة 55 درجة مئوية.
تظهر الفطريات البوغية قدرة استثنائية على تحمل الأشعة فوق البنفسجية ودرجة الحرارة
يعتقد الباحثون أن الغلاف الواقي حول كل بوغ يحميه عن طريق امتصاص الأشعة فوق البنفسجية وخلق حماية فيزيائية وكيميائية للبوغ بداخله. ويشيرون إلى أن هذا التكيف ربما ساعد النباتات الطحلبية المبكرة – وهي مجموعة النباتات التي تشمل الطحالب – على الانتقال من الموائل المائية إلى الأرض منذ حوالي 500 مليون سنة، مما مكنها من مقاومة أحداث الانقراض الجماعي المتعددة عبر تاريخ الأرض.
ولتحديد ما إذا كانت هذه الحماية الطبيعية ستصمد في الظروف الفضائية الفعلية، أطلق الفريق بعد ذلك نباتات بوغية خارج الغلاف الجوي للأرض.
إطلاق الطحلب وراء الستراتوسفير
في مارس 2022، سافرت مئات من النباتات البوغية إلى محطة الفضاء الدولية على متن المركبة الفضائية Cygnus NG-17. وقام رواد الفضاء بتركيب العينات على السطح الخارجي للمحطة، مما أدى إلى تعريضها للفضاء المفتوح لمدة إجمالية تبلغ 283 يومًا. عادت العينات لاحقًا إلى الأرض سبيس اكس CRS-16 في يناير 2023 وتم إعادتهم إلى المختبر للفحص.
يقول فوجيتا: “كنا نتوقع نجاة معدومة تقريبًا، لكن النتيجة كانت عكسية: فقد نجت معظم الجراثيم”. “لقد اندهشنا حقًا من المتانة الاستثنائية لهذه الخلايا النباتية الصغيرة.”
نتائج مذهلة للبقاء على قيد الحياة من محطة الفضاء الدولية
وقد عاش أكثر من 80% من الجراثيم طوال الرحلة بأكملها، ونبتت جميع تلك الجراثيم باستثناء 11% بمجرد إعادتها إلى المختبر. أظهرت الاختبارات على مستويات الكلوروفيل قراءات طبيعية لجميع الأصباغ تقريبًا، باستثناء انخفاض بنسبة 20% في الكلوروفيل أ – وهو مركب حساس للضوء – ولكن لا يبدو أن هذا الانخفاض يؤثر على صحة الجراثيم.
يقول فوجيتا: “توضح هذه الدراسة المرونة المذهلة للحياة التي نشأت على الأرض”.
وتساءل الباحثون عن المدة التي قد تستمر فيها الجراثيم بعد التعرض لمدة 9 أشهر، واستخدموا بياناتهم لبناء نموذج رياضي. وتشير تقديراتهم إلى أن الجراثيم يمكن أن تبقى على قيد الحياة لمدة تصل إلى 5600 يوم، أو ما يقرب من 15 عامًا، في ظل ظروف فضائية مماثلة. وشددوا على أن هذه مجرد حسابات أولية وأن هناك حاجة لتجارب إضافية بأحجام عينات أكبر لتحسين تلك التوقعات.
ويأمل الفريق أن تشجع النتائج التي توصلوا إليها العمل المستقبلي حول كيفية دعم التربة خارج كوكب الأرض لنمو النباتات وإثارة الاهتمام باستخدام الطحالب للمساعدة في بناء أنظمة زراعية مستدامة خارج الأرض.
نحو النظم البيئية المستقبلية خارج كوكب الأرض
“في نهاية المطاف، نأمل أن يفتح هذا العمل جبهة جديدة نحو بناء النظم البيئية في بيئات خارج كوكب الأرض مثل القمر و المريخ“يقول فوجيتا. “آمل أن تكون أبحاثنا حول الطحالب بمثابة نقطة انطلاق.”
iScience، ماينج وآخرون، “التسامح البيئي الشديد والقدرة على البقاء في الفضاء للطحالب، Physcomitrium patens”
معرف الهوية الرقمي: 10.1016/j.isci.2025.113827
تم دعم هذا العمل من خلال منحة DX بجامعة هوكايدو، وJSPS KAKENHI، ومركز علم الأحياء الفلكي التابع للمعاهد الوطنية للعلوم الطبيعية.
لا تفوت أي اختراق: انضم إلى النشرة الإخبارية SciTechDaily.
تابعونا على جوجل, يكتشف، و أخبار.
■ مصدر الخبر الأصلي
نشر لأول مرة على: scitechdaily.com
تاريخ النشر: 2025-11-20 18:02:00
الكاتب: Cell Press
تنويه من موقع “yalebnan.org”:
تم جلب هذا المحتوى بشكل آلي من المصدر:
scitechdaily.com
بتاريخ: 2025-11-20 18:02:00.
الآراء والمعلومات الواردة في هذا المقال لا تعبر بالضرورة عن رأي موقع “yalebnan.org”، والمسؤولية الكاملة تقع على عاتق المصدر الأصلي.
ملاحظة: قد يتم استخدام الترجمة الآلية في بعض الأحيان لتوفير هذا المحتوى.